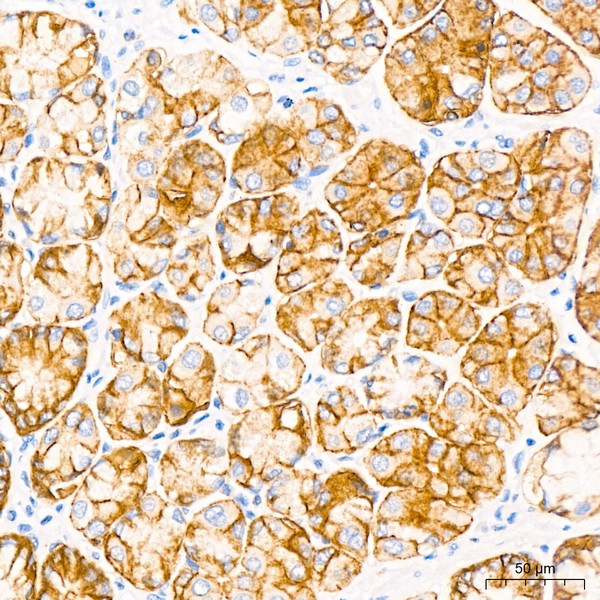
A20420: Claudin18.2 Rabbit mAb

Claudin18.2 Rabbit mAb (A20420)
$148.00 – $548.00
Abclonal Claudin18.2 Rabbit mAb (Catalog Number: A20420) encodes a member of the claudin family. Claudins are integral membrane proteins and components of tight junction strands.
- Details & Specifications
- References
| Catalog No. | A20420 |
|---|---|
| Product Name | Claudin18.2 Rabbit mAb (A20420) |
| Supplier Name | ABclonal, Inc. |
| Brand Name | Abclonal |
| Synonyms | SFTA5; SFTPJ |
| Gene Name | CLDN18 |
| Protein Name | CLDN18 |
| Uniprot/Swissprot ID | P56856 |
| Gene ID | 51208 |
| Clone | ARC5062-02 |
| Clonality | Monoclonal |
| Source/Host | Rabbit |
| Reactivity | Human |
| Conjugate | Unconjugated |
| Note | Products will be shipped from the warehouse in Massachusetts. Promotion is running from time to time. Welcome to send a request for quote to message@sydlabs.com. |
| Order Offline | Syd Labs, Inc. 4 Avenue E, Hopkinton, MA 01748 USA. Phone: 1-617-401-8149 Fax: 1-617-606-5019 Email: message@sydlabs.com |
Description
A20420: Claudin18.2 Rabbit mAb
This gene encodes a member of the claudin family. Claudins are integral membrane proteins and components of tight junction strands. Tight junction strands serve as a physical barrier to prevent solutes and water from passing freely through the paracellular space between epithelial or endothelial cell sheets, and also play critical roles in maintaining cell polarity and signal transductions. This gene is upregulated in patients with ulcerative colitis and highly overexpressed in infiltrating ductal adenocarcinomas. PKC/MAPK/AP-1 (protein kinase C/mitogen-activated protein kinase/activator protein-1) dependent pathway regulates the expression of this gene in gastric cells. Alternatively spliced transcript variants encoding different isoforms have been identified.
Immunogen Information about Claudin18.2 Rabbit mAb (A20420)
Immunogen:A synthetic peptide corresponding to a sequence within amino acids 1-100 of human CLDN18.2 (P56856-2).
Sequence:MSTTTCQVVAFLLSILGLAGCIAATGMDMWSTQDLYDNPVTSVFQYEGLWRSCVRQSSGFTECRPYFTILGLPAMLQAVRALMIVGIVLGAIGLLVSIFA
Gene ID:51208
Swiss prot:P56856
Synonyms:SFTA5; SFTPJ; Claudin18.2
Calculated MW:28kDa
Observed MW:Refer to figures
Images of Claudin18.2 Rabbit mAb (A20420)

Immunohistochemistry analysis of paraffin-embedded human stomach using CLDN18.2 Rabbit mAb (A20420) at dilution of 1:50 (40x lens).Perform high pressure antigen retrieval with 10 mM Tris/EDTA buffer pH 9.0 before commencing with IHC staining protocol.

Immunohistochemistry analysis of paraffin-embedded human stomach using CLDN18.2 Rabbit mAb (A20420) at dilution of 1:50 (40x lens).Perform high pressure antigen retrieval with 10 mM Tris/EDTA buffer pH 9.0 before commencing with IHC staining protocol.
Please remember our product information: Claudin18.2 Rabbit mAb (Catalog Number: A20420) Abclonal